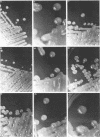

Abstract
Leuconostoc mesenteroides NRRL B-1355 produces dextrans and alternan from sucrose. Alternan is an unusual dextran-like polymer containing alternating α(1→6)/α(1→3) glucosidic bonds. Cultures were mutagenized with UV and ethyl methanesulfonate, and colony morphology mutants were selected on 10% sucrose plates. Colony morphology variants exhibited changes from parent cultures in the production of one or more glucosyltransferases (GTFs) and glucans. Mutants were characterized by measuring resistance of glucan products to dextranase digestion, by electrophoresis, and by high-pressure liquid chromatography of maltose acceptor products generated from sucrose-maltose mixtures. Some mutants produced almost pure fraction L dextran, and cultures exhibited a single principal GTF band on sodium dodecyl sulfate-acrylamide gels. Other mutants produced glucans enriched for alternan. Colony morphology characteristics (size, smoothness, and opacity) and liquid culture properties (clumpiness, color, and viscosity in 10% sucrose medium) were explained on the basis of GTF production. Three principal GTF bands were detected.
Full text
PDF








Images in this article
Selected References
These references are in PubMed. This may not be the complete list of references from this article.
- Bradford M. M. A rapid and sensitive method for the quantitation of microgram quantities of protein utilizing the principle of protein-dye binding. Anal Biochem. 1976 May 7;72:248–254. doi: 10.1016/0003-2697(76)90527-3. [DOI] [PubMed] [Google Scholar]
- Fu D. T., Robyt J. F. A facile purification of Leuconostoc mesenteroides B-512FM dextransucrase. Prep Biochem. 1990;20(2):93–106. doi: 10.1080/00327489008050182. [DOI] [PubMed] [Google Scholar]
- Jeanes A. Immunochemical and related interactions with dextrans reviewed in terms of improved structural information. Mol Immunol. 1986 Sep;23(9):999–1028. doi: 10.1016/0161-5890(86)90131-8. [DOI] [PubMed] [Google Scholar]
- Laemmli U. K. Cleavage of structural proteins during the assembly of the head of bacteriophage T4. Nature. 1970 Aug 15;227(5259):680–685. doi: 10.1038/227680a0. [DOI] [PubMed] [Google Scholar]
- Lawford G. R., Kligerman A., Williams T., Lawford H. G. Dextran biosynthesis and dextransucrase production by continuous culture of Leuconostoc mesenteroides. Biotechnol Bioeng. 1979 Jul;21(7):1121–1131. doi: 10.1002/bit.260210704. [DOI] [PubMed] [Google Scholar]
- Miller A. W., Eklund S. H., Robyt J. F. Milligram to gram scale purification and characterization of dextransucrase from Leuconostoc mesenteroides NRRL B-512F. Carbohydr Res. 1986 Mar 1;147(1):119–133. doi: 10.1016/0008-6215(86)85011-x. [DOI] [PubMed] [Google Scholar]
- Miller A. W., Robyt J. F. Detection of dextransucrase and levansucrase on polyacrylamide gels by the periodic acid-Schiff stain: staining artifacts and their prevention. Anal Biochem. 1986 Aug 1;156(2):357–363. doi: 10.1016/0003-2697(86)90266-6. [DOI] [PubMed] [Google Scholar]
- Miller A. W., Robyt J. F. Stabilization of dextransucrase from Leuconostoc mesenteroides NRRL B-512F by nonionic detergents, poly(ethylene glycol) and high-molecular-weight dextran. Biochim Biophys Acta. 1984 Mar 29;785(3):89–96. doi: 10.1016/0167-4838(84)90131-6. [DOI] [PubMed] [Google Scholar]
- Russell R. R. Glycosyltransferases of Streptococcus mutans strain Ingbritt. Microbios. 1978;23(93-94):136–146. [PubMed] [Google Scholar]
- Su D., Robyt J. F. Control of the synthesis of dextran and acceptor-products by Leuconostoc mesenteroides B-512FM dextransucrase. Carbohydr Res. 1993 Oct 4;248:339–348. doi: 10.1016/0008-6215(93)84139-w. [DOI] [PubMed] [Google Scholar]